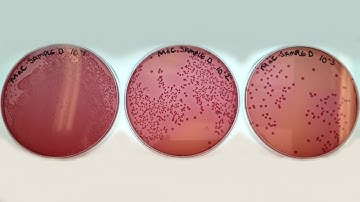
3. Level 3 Microbiology | Microbiology analysis of beef

⬇ DOWNLOAD NOW
Kalau muncul iklan pop-up, tutup lalu klik tombol kembali
Download lagu Faster Testing for Pathogenic E.coli in Beef secara gratis hanya untuk keperluan promosi. Dukung artis favorit kamu dengan membeli musik original di iTunes atau platform resmi lainnya.
 Faster Testing for Pathogenic E.coli in Beef #shorts
Faster Testing for Pathogenic E.coli in Beef #shorts
 Scientists develop patch to detect meat contaminated with E. coli
Scientists develop patch to detect meat contaminated with E. coli
 Detection of Escherichia coli (E. coli)_A Complete Procedure (ISO 9308-1 & ISO 16649)
Detection of Escherichia coli (E. coli)_A Complete Procedure (ISO 9308-1 & ISO 16649)
 E. Coli in Meat Tracking.mov
E. Coli in Meat Tracking.mov
3. Level 3 Microbiology | Microbiology analysis of beef
3. Level 3 Microbiology | Microbiology analysis of beef
 Testing rules out beef patties as source of E. coli outbreak, McDonald's says
Testing rules out beef patties as source of E. coli outbreak, McDonald's says
 Foodborne Pathogen Screening: Rapid Detection Of E. Coli O157:H7-Preview
Foodborne Pathogen Screening: Rapid Detection Of E. Coli O157:H7-Preview
 USDA FSIS Verification Testing Program of Beef Trimmings for E coli O157H7
USDA FSIS Verification Testing Program of Beef Trimmings for E coli O157H7